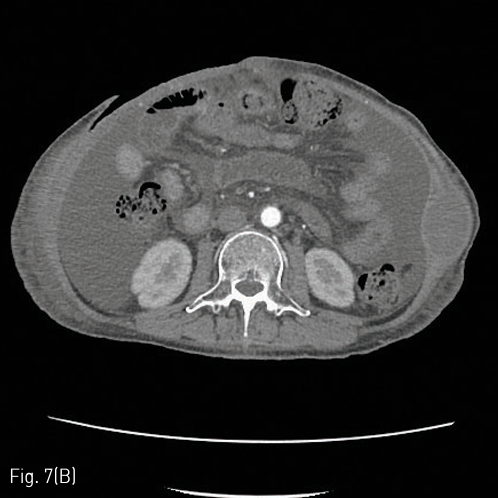

중심단어
Abdominal wall hematoma, embolization, complication
한글 초록
알코올성 간경화 및 간암을 진단받고 내원하지 않던 47세 여자 환자가 폐렴으로 입원하였다. 입원 2주째 복부 및 하지의 반상출혈 및 헤모글로빈감소 (9.7 → 5.8g/dL)로 시행한 복부 CT에서 우측 복벽의 혈종과 우측 심장골회선동맥(deep iliac circumflex artery)의 활동성 출혈병소가 발견되어 색전술을 시행하였다. 이후로 각각 7일째, 11일째, 15일째, 26일째와 29일째에 다발성으로 반복되는 복벽의 출혈로 각각 우측하복벽동맥, 우측엉덩허리동맥, 좌측심부대퇴동맥, 좌측 하복벽동맥, 우측 근횡격막동맥의 분지에 대해 색전술을 시행하였다. 최초 색전술 30일째 복벽의 피부 괴사가 발생하여 괴사조직 제거술을 시행하였으며, 피판성형술 계획하에 보존적 치료를 하고 있었다. 이후 환자는 재출혈은 없었으나 전신상태 악화된 상태로 입원 109일째 사망하였다.
영문 초록
A 47 year-old female patient was hospitalized due to pneumonia. The patient was diagnosed with alcoholic liver cirrhosis and hepatocellular carcinoma and underwent TACE 6 months ago. Two weeks after admission, ecchymoses of the lower abdomen and both thighs were noted and hemoglobin was decreased from 9.7 g/dL to 5.8 g/dL. On abdomen CT, huge abdominal wall hematoma and active bleeding at the right deep circumflex iliac artery were noted, which were immediately embolized with glue. After the embolization therapy, recurrentspontaneous active bleeding occurred at small branches of the right inferior epigastric artery, right iliolumbar artery, left deep femoral artery, left inferior epigastric artery, and right musculophrenic artery, all of which were treated with embolization therapy using glue and Gelfoam. 30 days after the initial embolization, skin defect with necrosis developed at the lower abdominal wall. The patient was planned to receive skin flap operation after the conservative treatment of antibiotics-resistant bacterial infection of the wound. However, although there were no additional bleedings, the patient expired due to general decline of state on the 109th day after admission.
Introduction
복벽에서 발생한 혈종은 복통의 다양한 원인 중 드물게 발생하는 경우에 해당하며, 일반적으로 복벽동맥이나 근육의 파열에 의해 발생한다. 외상이나 수술, 반복적 복수천자, 혈액응고장애를 가진 환자 등에서 잘 발생하는 것으로 알려져 있으며, 드물게는 자벌적으로도 발생하는 것으로 알려져 있다. 대부분의 환자들은 보존적 치료로 호전되나, 일부 경우에서는 활동성 출혈에 대한 색전술과 같은 침습적 치료가 필요한 경우도 있다. 본 증례에서는 만성 알코올성 간경화 환자에서 자발적으로 발생한 복벽 혈종에 대해 Glue와 Gelfoam을 이용한 응급색전술을 반복적으로 시행하였으며, 이에 대한 합병증으로 복벽의 괴사 및 결손이 발생하였고, 보존적 치료를 지속하던 중 전신 상태의 악화로 환자가 사망하였다.
Case report
증례
47세/여자
임상소견
알코올성 간경화증에 합병된 간암환자가 폐렴으로 입원(Child Pugh Class C, 11)하여 치료받던 중 반상출혈 및 헤모글로빈의 감소가 발생하여 진료의뢰되었다.
진단명
Recurrent spontaneous multifocal abdominal wall hemorrhage.
영상소견
입원 중 발생한 복부와 하지의 반상출혈 및 헤모글로빈 감소로 시행한 CT에서 우측 장골회선동맥(deep circumflex iliac artery)에서의 활동성 출혈 및 우측 복벽의 혈종(13 x 9cm)이 확인되어 (Fig. 1A), Glue를 이용하여 색전술을 시행하였다(Fig. 1B). 최초 증상발생일을 기준으로 7일째 재발한 증상으로 촬영한 CT에서 혈종의 크기가 증가하였으며 (26 x 12cm), 우측 하복벽동맥(inferior epigastric artery)의 출혈병소가 관찰되어(Fig. 2A), Glue를 이용하여 2차 색전술을 시행하였다 (Fig. 2B). 다시 11일째 증상 재발하여 시행한 CT에서 혈종은 좌측 복벽에도 발생한 상태였으며 활동성 출혈병소는 우측에서만 확인되어 (Fig. 3A) 3차 응급색전술을 시행하였다. 혈관조영시 우측 장요동맥(iliolumbar artery)에서 혈관외유출이 확인되어 다시 Glue를 이용하여 색전술을 시행하였으며 (Fig. 3B), 좌측 복벽혈종의 원인 혈관은 보이지 않았다. 다시 15일째 같은 원인으로 시행한 CT에서 복벽혈종은 좌우가 연결되어 복강내 장기들을 압박하고 있었으며 크기는 약 31 x 15cm까지 커져있는 상태였고 (Fig. 4A), 좌측 서혜부에 활동성 출혈병소가 확인되어(Fig. 4B) 응급혈관조영술을 시행하였다. 혈관조영술에서 근위부 대퇴동맥과 대퇴회선 동맥(circumflex femoral artery)의 작은 분지에서 출혈병소가 확인되었으며, 각각에 대해 Gelfoam을 이용하여 색전술을 시행하였다 (Fig. 4C). 다시 같은 원인으로 26일째 CT 시행하였으며, 혈종은 더욱 커져 약 34 x 18cm까지 커지고 (Fig. 5A), 배꼽 근방에서는 피부 결손이 발생하였으며, 복강내 장기의 압박으로 양측 수신증까지 발생한 상태였다. 좌측 하복벽동맥에서 기시하는 출혈병소가 의심되었기에 다시 혈관조영술을 시행하였으며, 해당 동맥에 대해 Gelfoam을 이용하여 색전술을 시행하였다 (Fig. 5B). 추가적으로 좌측 대퇴동맥 카테터 삽입부에 가성동맥류가 형성된 것이 확인되었고 보존적으로 추적관찰하기로 하였다. 최초 색전술을 기준으로 29일째 6번째 CT를 촬영하였으며, 우측 상복벽에 새롭게 출혈병소가 확인되었다 (Fig. 6A). 다시 혈관조영술을 시행하였으며, 우측 내흉동맥에서 기시하는 근횡격막동맥 (musculophrenic artery)의 분지에서 출혈병소가 확인되어 Glue를 이용하여 색전술을 시행하였다 (Fig. 6B).
시술방법 및 재료
우측 대퇴동맥을 Seldinger method로 천자한 뒤, 5Fr sheath (Accu-sheath, SungWon Medical, Cheongju, Korea)를 삽입하였다. 0.035”유도철선(Radiofocus guidewire, Terumo corp., Tokyo, Japan)과 Cobra catheter (C2, Torcon NB advantage catheter, Cook Medical, Bloomington,IN, SA)를 이용하여 각각의 출혈혈관에 대해 선택적 혈관조영술을 실시하였다. 각각의 출혈병변에 대해서는 1.98Fr microcatheter (Parkway, Asahi Intecc,
Nagoya, Japan)와 0.014”microwire (Streaming, Asahi Intecc, Nagoya, Japan)를 이용하여 Glue 및 Gelfoam을 이용하여 색전술을 시행하였다.
추적관찰
이후 환자는 복벽 혈종 및 피부 결손에 대해 괴사조직제거술을 시행하고 성형외과적 피판성형술 계획 및 보존적 치료하였으며 (Fig. 7A, 7B), 증상재발 없이 경과 관찰중이었으나, 입원 109일째 전신상태 및 폐렴 합병증의 악화로 사망하였다
Fig 1A
(A) Abdomen CT shows hematoma of right abdominal wall (about 13 x 9cm) and an active bleeding focus from the small branch of the right deep iliac circumflex artery (arrow).
Fig 1B
(B) Multifocal extravasation of contrast media from the small branches on right deep iliac circumflex angiography (arrows), which was followed by glue embolization.
Fig 2A
(A) 7 days later, marked increase of size of the abdominal wall hematoma (about 26 x 12cm) was noted on follow-up abdomen CT, and another active bleeding focus from the right inferior epigastric artery was noted.
Fig 2B
(B) Multifocal extravasation of contrast media from the small branches on right inferior epigastric angiography could be noted(arrows), and glue embolization was performed.
Fig 3A
(A) 4 days later, more size increase and another active bleeding focus of the right abdominal wall hematoma were noted on follow-up abdomen CT. New hematoma at left side of the abdominal wall without any definite detected bleeding focus on the CT scan.
Fig 3B
(B) Extravasation of contrast media from the iliolumbar artery of the posterior division of the right internal iliac artery was successfully treated with glue embolization.
Fig 4A
(A) 4 days later, the size of the abdominal wall hematoma was more increased (about 31 x 15cm), and posterior displacement of the visceral organs was noted on follow-up abdomen CT.
Fig 4B
(B) Another active bleeding focus was detected at left lower abdominal wall near by the left suprapubic inguinal area.
Fig 4C
(C) Additional extravasation foci were noted at branches of the left proximal deep femoral and femoral circumflex arteries, which were treated with glue embolization.
Fig 5A
(A) 11 days later, the size of the abdominal wall hematoma is more increased with inferior extension (about 34 x 18cm), and another active bleeding is noted at the lower abdominal wall. The bleeding focus was from the left inferior epigastric arterial branch on angiography, and treated with gelfoam embolization(white arrow).
Fig 5B
(B) Pseudoaneurysm formation is noted at previous angiographic catheterization site of the left common femoral artery (black arrow).
Fig 6A
(A) 3 days later, another active bleeding focus is noted at the right upper abdominal wall. Right hydronephrosis is developed due to extrinsic compression of the right proximal ureter by the abdominal wall hematoma.
Fig 6B
(B) Extravasation was noted from the small branch of right musculophrenic artery of the right internal thoracic artery, which was treated with glue embolization.
Fig 7A
(A) Large skin defect with necrosis was developed due to the recurrent abdominal wall hemorrhage and ischemic tissue injury resulted from the embolization therapy. Originally skin graft was planned but due to an isolation of a resistant strain from the necrotic area, the skin defect was treated with conservative management after debridement.
Fig 7B
(B) A skin defect could be observed in the anterior abdominal wall in the abdominal CT taken on day 52 from the initial embolization therapy with all hematomas of the abdominal wall removed and no recurrent bleeding.
고찰
복벽에서 발생한 출혈의 초치료로써 이용되는 선택적 혈관조영술 및 색전술은 효과적이며 비교적 안전한 치료방법으로 알려져있다. Glue를 이용한 혈관색전술은 영구적인 혈관색전을 야기하므로 비선택혈관의 색전이 발생할 경우 합병증의 가능성이 높고, 카테터내색전이 발생할 가능성이 있어 시술자의 경험이 색전술의 성공에 중요한 요소로 작용한다. 그러나, 본 증례에서와 같이 응급상황에서 다발성, 다회성의 혈관출혈이 발생하는 경우 색전술 자체는 성공적으로 시행하더라도 누적된 혈관색전의 영향으로 피부괴사와 같은 합병증이 발생할 가능성이 높아지며, 진료과와의 협의 및 환자경과에 대한 정보 교환도 원활하지 못하게 진행되는 경우가 있어, 안전한 색전술의 시행에 제한점이 존재하는 것이 현실이다. 따라서, 이와 유사한 다발성 증례를 치료함에 있어서, 가능한 최대한 선택적인 혈관색전술을 시행하는 것과 적합한 색전물질을 선택하는 것이 더욱 중요한 요소로 작용하게 된다. 또한, 이 증례에서 본 것처럼 커다란 크기의 혈종 및 허혈성 손상이나 감염이 발생한 경우 수술적 치료의 적응증이 되므로, 진료과와 긴밀한 협조하에 수술적 치료나 혈종제거술을 시행하는 것이 합병증의 예방 및 치료에 필요할 것으로 생각된다.
참고문헌
1. Palatucci V, Lombardi G, Lombardi L, Giglio F, Giordano F, Lombardi D. Spontaneous muscle haematomas: management of 10 cases. Transl Med UniSa 2014;10:13-17
2. Bilbao JI, Mart?nez-Cuesta A, Urtasun F, Cos?n O. Complications of Embolization, Semin Intervent Radiol 2006;23:126-142
3. Bailey MA, McPherson SJ, Troxler MA, Peach AH, Patel JV, Scott DJ. Ischemic Skin Ulceration Complicating Glue Embolization of Type II Endoleak after Endovascular Aneurysm Repair. J Vasc Interv Radiol 2011;22:163-167
4. Koh S, Maki EJ, Kolbeck KJ, Farsad K. Skin ischemia and ulceration as a complication of inferiorphrenic artery embolization for hepatocellular carcinoma. Radiol Case Rep 2018;13: 648-651
Citations
Citations to this article as recorded by